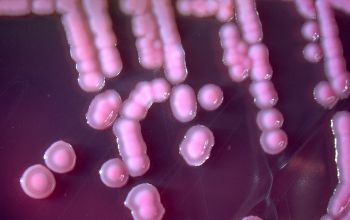
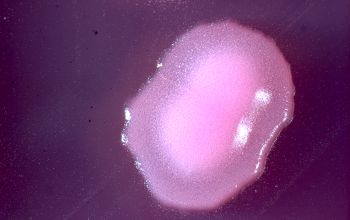

Yersinia enterocolitica
-
General information
Taxonomy
Family: Enterobacteriaceae
Yersinia has 3 species of which are pathogenic for humans, namely
Y. enterocolitia, Y. pseudotuberculosis and Y. pestis
Natural habitats
Comes in all animal species, but has also been isolated from (drinking) water, soil and vegetables, also from animal products such as raw milk, cream, ice cream, beef, pigs oysters, lamb and chicken.
Clinical significance
They can cause yersiniosis in human and animals and they are a significant food-borne pathogen.
Infection usually lead to mild self-limiting enterocolitis, terminal ileitis and adenitis in humans.
Symptoms may include watery or bloody diarrhea and fever.
The infections are sometimes followed by chronic inflammatory diseases such as arthritis and erythema nodosum
Sepsis may occur with a high mortality in debilitated patients with severe underlying diseases.
Yersinia can also occur in pus of deep abscesses.
-
Gram stain
Gram negative coccoid rods,
1.0-3.0 x 0.5-0.8 µm,
sometimes bipolar colored.
-
Culture characteristics
-
Facultative anaerobic
BA: colonies are gray and smooth, some stains form a yellow to light yellow pigment.
Colonies grow more slowly and are small, gray-white, opaque, smooth and 0.1 to 1.0 mm in diameter after 24 hours of incubation
McC: growth, non lactose fermenter
CIN agar / Yersinia selective agar: clear colonies with red center,
so-called "bulls-eye"
BBAØ: growth
motility:
< 30°C peritrichous flagella
> 30°C non motile
-
-
Characteristics
-
References
James Versalovic et al.(2011) Manual of Clinical Microbiology 10th Edition
Karen C. Carrol et al (2019) Manual of Clinical Microbiology, 12th Edition